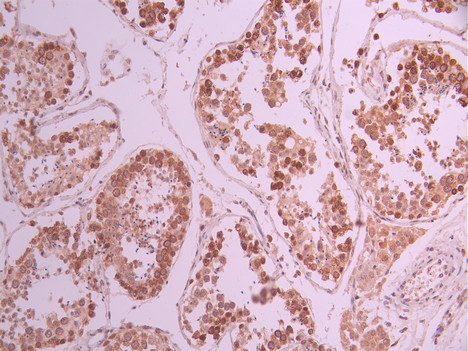

SMC3 Recombinant Monoclonal Antibody
-
中文名稱:SMC3 Recombinant Monoclonal Antibody
-
貨號(hào):CSB-RA966408A0HU
-
規(guī)格:¥1320
-
圖片:
-
Western Blot
Positive WB detected in:A431 whole cell lysate(30μg), Jurkat whole cell lysate(30μg), SW620 whole cell lysate(30μg), Hela whole cell lysate(30μg), NIH/3T3 whole cell lysate(30μg), Rat brain tissue lysate(30μg)
All lanes: SMC3 antibody at 1:1000
Secondary
Goat polyclonal to rabbit IgG at 1/40000 dilution
Predicted band size: 142 kDa
Observed band size: 142 kDa
Exposure time:40s -
IHC image of CSB-RA966408A0HU diluted at 1:100 and staining in paraffin-embedded human glioma cancer performed on a Leica BondTM system. After dewaxing and hydration, antigen retrieval was mediated by high pressure in a citrate buffer (pH 6.0). Section was blocked with 10% normal goat serum 30min at RT. Then primary antibody (1% BSA) was incubated at 4°C overnight. The primary is detected by a Goat anti-rabbit polymer IgG labeled by HRP and visualized using 0.05% DAB.
-
IHC image of CSB-RA966408A0HU diluted at 1:100 and staining in paraffin-embedded human testis tissue performed on a Leica BondTM system. After dewaxing and hydration, antigen retrieval was mediated by high pressure in a citrate buffer (pH 6.0). Section was blocked with 10% normal goat serum 30min at RT. Then primary antibody (1% BSA) was incubated at 4°C overnight. The primary is detected by a Goat anti-rabbit polymer IgG labeled by HRP and visualized using 0.05% DAB.
-
Immunofluorescence staining of A431 cell with CSB-RA966408A0HU at 1:50, counter-stained with DAPI. The cells were fixed in 4% formaldehyde, permeabilized using 0.2% Triton X-100 and blocked in 10% normal Goat Serum. The cells were then incubated with the antibody overnight at 4°C. The secondary antibody was Alexa Fluor 488-congugated AffiniPure Goat Anti-Rabbit IgG(H+L).
-
Overlay Peak curve showing Raji cells stained with CSB-RA966408A0HU (red line) at 1:100. The cells were fixed in 4% formaldehyde and permeated by 0.2% TritonX-100 for 10min. Then 10% normal goat serum to block non-specific protein-protein interactions followed by the antibody (1ug/1*106cells) for 45min at 4℃. The secondary antibody used was FITC-conjugated goat anti-rabbit IgG (H+L) at 1/200 dilution for 35min at 4℃.Control antibody (green line) was Rabbit IgG (1ug/1*106cells) used under the same conditions. Acquisition of >10,000 events was performed.
-
-
其他:
產(chǎn)品詳情
-
Uniprot No.:
-
基因名:
-
別名:Structural maintenance of chromosomes protein 3 (SMC protein 3) (SMC-3) (Basement membrane-associated chondroitin proteoglycan) (Bamacan) (Chondroitin sulfate proteoglycan 6) (Chromosome-associated polypeptide) (hCAP), SMC3, BAM BMH CSPG6 SMC3L1
-
反應(yīng)種屬:Human, Mouse, Rat
-
免疫原:A synthesized peptide from human SMC3 protein
-
免疫原種屬:Homo sapiens (Human)
-
標(biāo)記方式:Non-conjugated
-
克隆類型:Monoclonal
-
抗體亞型:Rabbit IgG
-
純化方式:Affinity-chromatography
-
克隆號(hào):12B7
-
濃度:It differs from different batches. Please contact us to confirm it.
-
保存緩沖液:Preservative: 0.03% Proclin 300
Constituents: 50% Glycerol, 0.01M PBS, PH 7.4 -
產(chǎn)品提供形式:Liquid
-
應(yīng)用范圍:ELISA, WB, IHC, IF, FC
-
推薦稀釋比:
Application Recommended Dilution WB 1:500-1:2000 IHC 1:50-1:200 IF 1:50-1:200 FC 1:50-1:200 -
Protocols:
-
儲(chǔ)存條件:Upon receipt, store at -20°C or -80°C. Avoid repeated freeze.
-
貨期:Basically, we can dispatch the products out in 1-3 working days after receiving your orders. Delivery time maybe differs from different purchasing way or location, please kindly consult your local distributors for specific delivery time.
-
用途:For Research Use Only. Not for use in diagnostic or therapeutic procedures.
相關(guān)產(chǎn)品
靶點(diǎn)詳情
-
功能:Central component of cohesin, a complex required for chromosome cohesion during the cell cycle. The cohesin complex may form a large proteinaceous ring within which sister chromatids can be trapped. At anaphase, the complex is cleaved and dissociates from chromatin, allowing sister chromatids to segregate. Cohesion is coupled to DNA replication and is involved in DNA repair. The cohesin complex plays also an important role in spindle pole assembly during mitosis and in chromosomes movement.
-
基因功能參考文獻(xiàn):
- H2 inhibited lung cancer progression through down-regulating SMC3. PMID: 29852353
- We identified a large number of mutations in the CC region of both Smc1 and Smc3... we introduced them to the yeast Smc1 and Smc3 CC domains and characterized the effect of these mutant alleles on cohesin's function. We identified a missense mutation in the region of the kink domain of Smc3, which was previously identified in kidney carcinoma PMID: 27307603
- Results show that SMC3 is upregulated in asthma patients and suggest that it may play an important role in atopic asthma development, especially in asthma epithelial-mesenchymal transition. PMID: 25515564
- Data show that histone deacetylase 8 (HDAC8) inhibition led to accumulation of acetylated-SMC3 protein but had no influence on the transcription of estrogen-responsive genes. PMID: 27072133
- De novo heterozygous mutations in SMC3 cause a range of Cornelia de Lange syndrome-overlapping phenotypes PMID: 25655089
- cohesin's proposed DNA exit gate is formed by interactions between Scc1 and the coiled-coil region of Smc3. PMID: 25414306
- Cross-sectional deep-sequencing analysis for clonal hierarchy demonstrated STAG2, SMC3, and RAD21 mutations to be ancestral in 18%, 18%, and 47% of cases, respectively, and each expanded to clonal dominance concordant with disease transformation PMID: 25006131
- Mutations in SMC3 is associated with acute myeloid leukemia. PMID: 24335498
- Upon knock-down of human SMC1, much of SMC3 remains stable, accumulates in the cytoplasm and does not associate with other cohesin proteins. PMID: 23776448
- SMC3 and separase are upregulated and securin is downregulated in malignant transformation of BEAS-2B cells induced by coal tar pitch smoke extracts. PMID: 21126432
- these studies clearly suggest that bamacan interacts with the vaccinia virus-N1L and such interactions seem to play a positive role in promoting the viral growth and perhaps contribute to the virulence of VV in neural cells. PMID: 19444697
- identification as target for beta-catenin/T-cell factor 4 transactivation pathway PMID: 12651860
- Hinderin is a novel binding partner of SMC3. Based on its ability to modulate SMC1/SMC3 interaction we postulate that Hinderin affects the availability of SMC3 to engage in the formation of multimeric protein complexes PMID: 15656913
- RPGR-ORF15, which is mutated in retinitis pigmentosa, associates with SMC3. PMID: 16043481
- RhoB and cAMP cis-acting response elements -BPa two known oncogenic mediators whose expression is significantly increased following SMC3 overexpression play a significant role in mediating SMC3 tumorigenesis PMID: 16156898
- SMC3 deficiency affects chromosomal stability leading to the activation of p53-dependent mitotic checkpoint. PMID: 17081288
- Mutations in SMC3 cause a mild variant of cornelia de Lange syndrome with predominant mental retardation PMID: 17273969
- phosphorylation of a core cohesin subunit SMC3 by ATM plays an important role in DNA damage PMID: 18442975
- This study identified a molecular target for the acetyltransferase Eco1 and revealed that Smc3 acetylation is a conserved mechanism in regulating sister chromatid cohesion. PMID: 18614053
- There were greater levels of chondroitin sulphate WF6 epitope in gingival crevicular fluid from destructive sites of patients with chronic periodontitis compared with non-destructive sites of patients with gingivitis or chronic periodontitis. PMID: 18727658
- Data describe alterations of myocardial intercellular and cell-matrix contacts in hypertrophic tissue, and show intracellular translocation of beta-catenin, alpha-actinin and chondroitin sulfate proteoglycan 6 in both an animal model and in LVH patients. PMID: 19094982
顯示更多
收起更多
-
相關(guān)疾病:Cornelia de Lange syndrome 3 (CDLS3)
-
亞細(xì)胞定位:Nucleus. Chromosome. Chromosome, centromere.
-
蛋白家族:SMC family, SMC3 subfamily
-
數(shù)據(jù)庫(kù)鏈接:
Most popular with customers
-
-
YWHAB Recombinant Monoclonal Antibody
Applications: ELISA, WB, IHC, IF, FC
Species Reactivity: Human, Mouse, Rat
-
Phospho-YAP1 (S127) Recombinant Monoclonal Antibody
Applications: ELISA, WB, IHC
Species Reactivity: Human
-
-
-
-
-